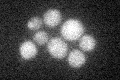
YMR299C
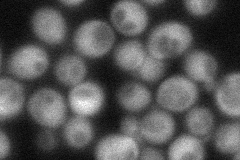
YMR299C
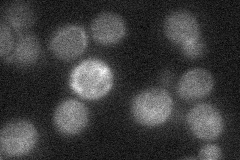
YMR299C
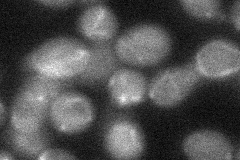
YMR299C

View description
Dynein light intermediate chain (LIC); localizes with dynein, null mutant is defective in nuclear migration
Localization:
Intensity:
Fold change:
Significance:
-
C’ GFP library in SD
cytosol18.27 -
N' NOP1pr-GFP in SD
cytosol59.0847 -
N' TEF2pr-mCherry in SD

cytosol19.8433 -
N' NATIVEpr-GFP in SD
below threshold21.9482 -
N' TEF2pr-VC and Cyto-VN in SD
below threshold28.7561 -
C’ GFP library in SD+DTT

cytosol16.870.92No -
C’ GFP library in SD+H2O2

cytosol19.081.04No -
C’ GFP library in Starvation Media

cytosol18.160.99No -
C’ GFP library on the background of Pup2-DaMP

cytosol -
C’ GFP library on the background of CCT mutant

cytosol18.34831.00377No
